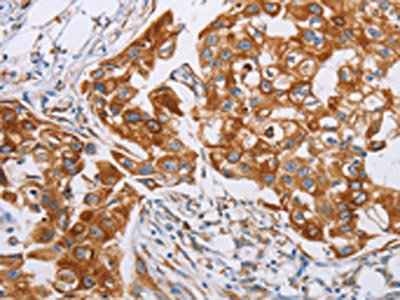

CDC27 Antibody
-
中文名稱:CDC27兔多克隆抗體
-
貨號:CSB-PA084372
-
規(guī)格:¥1100
-
圖片:
-
The image on the left is immunohistochemistry of paraffin-embedded Human lung cancer tissue using CSB-PA084372(CDC27 Antibody) at dilution 1/20, on the right is treated with synthetic peptide. (Original magnification: ×200)
-
The image on the left is immunohistochemistry of paraffin-embedded Human breast cancer tissue using CSB-PA084372(CDC27 Antibody) at dilution 1/20, on the right is treated with synthetic peptide. (Original magnification: ×200)
-
Gel: 6%SDS-PAGE, Lysate: 40 μg, Lane: K562 cells, Primary antibody: CSB-PA084372(CDC27 Antibody) at dilution 1/400, Secondary antibody: Goat anti rabbit IgG at 1/8000 dilution, Exposure time: 1 minute
-
-
其他:
產(chǎn)品詳情
-
Uniprot No.:
-
基因名:
-
別名:ANAPC3 antibody; Anaphase Promoting Complex 3 antibody; Anaphase promoting complex protein 3 antibody; Anaphase Promoting Complex Subunit 3 antibody; Anaphase-promoting complex subunit 3 antibody; APC 3 antibody; APC3 antibody; Cdc 27 antibody; Cdc27 antibody; CDC27 homolog antibody; CDC27_HUMAN antibody; CDC27Hs antibody; Cell Division Cycle 27 antibody; Cell division cycle protein 27 homolog antibody; D0S1430E antibody; D17S978E antibody; H NUC antibody; H-NUC antibody; HNUC antibody; Nuc2 homolog antibody
-
宿主:Rabbit
-
反應(yīng)種屬:Human,Mouse,Rat
-
免疫原:Synthetic peptide of Human CDC27
-
免疫原種屬:Homo sapiens (Human)
-
標(biāo)記方式:Non-conjugated
-
抗體亞型:IgG
-
純化方式:Antigen affinity purification
-
濃度:It differs from different batches. Please contact us to confirm it.
-
保存緩沖液:-20°C, pH7.4 PBS, 0.05% NaN3, 40% Glycerol
-
產(chǎn)品提供形式:Liquid
-
應(yīng)用范圍:ELISA,WB,IHC
-
推薦稀釋比:
Application Recommended Dilution ELISA 1:1000-1:2000 WB 1:200-1:1000 IHC 1:25-1:100 -
Protocols:
-
儲存條件:Upon receipt, store at -20°C or -80°C. Avoid repeated freeze.
-
貨期:Basically, we can dispatch the products out in 1-3 working days after receiving your orders. Delivery time maybe differs from different purchasing way or location, please kindly consult your local distributors for specific delivery time.
-
用途:For Research Use Only. Not for use in diagnostic or therapeutic procedures.
相關(guān)產(chǎn)品
靶點(diǎn)詳情
-
功能:Component of the anaphase promoting complex/cyclosome (APC/C), a cell cycle-regulated E3 ubiquitin ligase that controls progression through mitosis and the G1 phase of the cell cycle. The APC/C complex acts by mediating ubiquitination and subsequent degradation of target proteins: it mainly mediates the formation of 'Lys-11'-linked polyubiquitin chains and, to a lower extent, the formation of 'Lys-48'- and 'Lys-63'-linked polyubiquitin chains.
-
基因功能參考文獻(xiàn):
- CDC27 facilitated cells invasion and metastasis via Twist pathway, leading to initiation of epithelial-mesenchymal transition and silencing of Twist expression could reverse this process. PMID: 30308498
- mir-218-2 promotes glioblastomas growth, invasion and drug resistance by targeting CDC27 expression. PMID: 27974673
- The levels of CDC20 and CylinB1 increased and the levels of Ku70 and APC3 decreased after irradiation. APC/C(Cdh1) is involved in regulation of radiosensitivity in human NPC CNE-1 cells. PMID: 28004426
- Data indicate that UBE2S and APC3 co-regulate the expression level of P21 at G2/M check point via the ubiquitin-proteasome system. PMID: 28257844
- Cdc27 is a novel binding partner of Elmo1.Cdc27-Elmo1 has a cellular role independent from the Elmo-Dock1-Rac signal module. PMID: 26882976
- miR-27a could modulate proliferation and radiosensitivity of TNBC cells. CDC-27 is a direct target of miR-27a and its downregulation conferred increased radioresistance of the cells. PMID: 25943633
- These findings suggested that polymorphisms in cdc27 may contribute to the susceptibility of BC though functional studies are needed to further elucidate the underling mechanisms of the associations PMID: 25680405
- The structures show how one APC16 binds asymmetrically to the symmetric APC3 dimer and, together with biochemistry and prior data, explain how APC16 recruits APC7 to APC3. PMID: 25490258
- Low cdc27 and high securin expression predict short survival for breast cancer patients. PMID: 23755904
- Down-regulation of CDC27 protein is associated with radiation resistance. PMID: 23923534
- Data indicate that additional density present in the anaphase-promoting complex (APC/C) structure, proximal to Apc3/Cdc27 of the (tetratricopeptide repeat) lobe, is assigned to the TPR subunit Apc7, a subunit specific to vertebrate APC/C. PMID: 23078409
- the biochemical, structural, and cellular determinants of the novel interaction between MCPH1 and Cdc27 and suggest that this interaction may occur within the larger context of MCPH1-APC/C. PMID: 22139841
- phosphorylation of Cdc27 by CKII is involved in TGF-beta-induced activation of APC. PMID: 21209074
- the spindle checkpoint may regulate CDC27/APC activity at mitosis PMID: 12429948
- HOXC10 co-immunoprecipitates the APC subunit CDC27, and its in vitro degradation is reduced in APC-depleted extracts or by competition with the APC substrate cyclin A. PMID: 12853486
- The interaction is direct and is mediated by the tandem BRCA1 C-terminal domains of MDC1 and the C terminus of the Cdc27 (APC3) subunit of the anaphase-promoting complex/cyclosome. PMID: 17827148
顯示更多
收起更多
-
亞細(xì)胞定位:Nucleus. Cytoplasm, cytoskeleton, spindle.
-
蛋白家族:APC3/CDC27 family
-
數(shù)據(jù)庫鏈接:
Most popular with customers
-
-
YWHAB Recombinant Monoclonal Antibody
Applications: ELISA, WB, IHC, IF, FC
Species Reactivity: Human, Mouse, Rat
-
Phospho-YAP1 (S127) Recombinant Monoclonal Antibody
Applications: ELISA, WB, IHC
Species Reactivity: Human
-
-
-
-
-